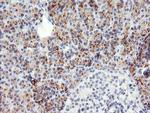
SNAI2 Antibody in Immunohistochemistry (Paraffin) (IHC (P))

Search
OriGene
SNAI2 Monoclonal Antibody (OTI1G7), TrueMAB™
{{$productOrderCtrl.translations['antibody.pdp.commerceCard.promotion.promotions']}}
{{$productOrderCtrl.translations['antibody.pdp.commerceCard.promotion.viewpromo']}}
{{$productOrderCtrl.translations['antibody.pdp.commerceCard.promotion.promocode']}}: {{promo.promoCode}} {{promo.promoTitle}} {{promo.promoDescription}}. {{$productOrderCtrl.translations['antibody.pdp.commerceCard.promotion.learnmore']}}
产品信息
TA800196
种属反应
宿主/亚型
分类
类型
克隆号
抗原
偶联物
形式
浓度
纯化类型
保存液
内含物
保存条件
运输条件
靶标信息
Slug, a member of the Snail family of C2H2-type zinc finger transcription factors, was initially identified to be involved in epithelial-mesenchymal transitions as well as the formation of the neural tube during vertebrate embryogenesis. Like Snail, Slug transcription can be induced by growth factors such as FGF, BMP, and TGF-beta. Once expressed, Slug will bind E-box regions of promoters and repress transcription of genes such as E-cadherin and Claudin-1. More recently, its expression in breast, esophogeal, and colorectal carcinomas has been correlated with poor prognosis for survival. Furthermore, Slug can protect hemopoietic progenitor cells from radiation-induced apoptosis by repressing the p53-mediated transcription of Puma, a BH3-only antagonist of the anti-apoptotic members of the Bcl-2 family.
仅用于科研。不用于诊断过程。未经明确授权不得转售。
生物信息学
蛋白别名: MGC10182; Neural crest transcription factor Slug; Protein snail homolog 2; slug (chicken homolog), zinc finger protein; snail family zinc finger 2; snail homolog 2; Zinc finger protein SNAI2
基因别名: SLUG; SLUGH; SLUGH1; SNAI2; SNAIL2; WS2D
UniProt ID: (Human) O43623
Entrez Gene ID: (Human) 6591